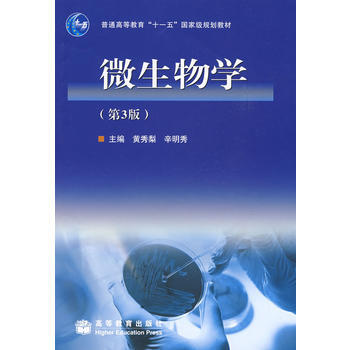
包邮 微生物学（附盘） 黄秀梨 辛明秀 高等教育出版社 第三版 第3版 高教版 pdf epub mobi 电子书 下载

具体描述
基本信息
书名:活细胞成像(第二版)
定价:240.00元
作者:〔美〕R.D.戈德曼,〔英〕J.R.斯瓦罗,〔美〕
出版社:科学出版社
出版日期:2012-05-01
ISBN:9787030341198
字数:1123000
页码:739
版次:1
装帧:平装
开本:16开
商品重量:1.680kg
编辑推荐
内容提要
《活细胞成像(第二版)》包括活细胞成像的基础理论、新发展和实验指南。系统介绍了荧光蛋白的各种光谱变体,表达载体构建,活细胞成像用CCD相机的类型及工作原理,常用显微镜系统(如宽视场、共聚焦和转盘式共聚焦),以及新一代超分辨率显微镜系统,图像处理方法和软件,各种定量成像等分析分子动力学的方法。作为实验指南,《活细胞成像(第二版)》以各种不同细胞和生物体为对象给出了具体的成像实例,包括染色质、蛋白质和RNA的标记定位,蛋白质与蛋白质相互作用检测,金属离子和pH的生物传感器,脂类物质的标记等。《活细胞成像(第二版)》既可以作为活细胞成像领域的入门读物,又可以作为人类、动物、植物、昆虫和微生物等专业科研人员的理论基础读物和具体实验操作指南。
目录
译者序
前言
各章附加的影像
上篇 活细胞成像的检测和方法
第1章 荧光蛋白的跟踪与检测
第2章 荧光蛋白融合的构建和表达
第3章 用线性聚丙烯酸阻抗细胞与基底黏附的微图案化处理技术
第4章 CCD相机在活细胞荧光成像中的应用
第5章 荧光干扰技术研究活细胞中蛋白质的运动性和分子动态:FRAP、Photoacivation、Photoconversin和FLIP
第6章 细胞中蛋白质状态成像
第7章 用于高分辨率活细胞成像的多功能多色彩全内反射荧光及转盘式共聚焦显微成像系统
第8章 共聚焦显微镜、去卷积和结构照明方法
第9章 生物成像和微观机械性质测量中的原子力显微镜
第10章 OMX,一个多模式多通道宽场成像的新平台
第11章 数字扫描激光光片荧光显微镜
第12章 活体细胞荧光相关光谱初步
第13章 动态移动细胞和粒点的跟踪及定量分析
第14章 测量细胞材料特性的成像技术
第15章 细胞动态的计算图像分析——粒点追踪的案例分析
第16章 显微成像中的软件工具、数据结构及控制界面
第17章 以哺乳动物活细胞为例介绍高通量显微镜
下篇 活细胞和生物体的成像
第18章 哺乳动物细胞的活体成像
第19章 酵母活细胞成像
第20章 线虫的活细胞成像
第21章 植物活细胞成像
第22章 果蝇活细胞成像技术的拓展
第23章 乳腺癌鼠模型肿瘤基质相互作用在转盘式共聚焦显微镜下的动态和长时间活体成像
第24章 活体肿瘤的高分辨多光子成像
第25章 四半胱氨酸标签与双砷染料标记的活细胞光学显微镜与电子显微镜的关联成像
第26章 小鼠正常组织和疾病组织活体成像研究
第27章 活细胞中脂类的成像
第28章 染色体被乳糖操纵基因标记的哺乳动物细胞系的发展
第29章 活细胞中基因表达的成像
第30章 在哺乳动物培养细胞中研究有丝分裂
第31章 中间纤维蛋白在活细胞内的成像
第32章 表达和分析绿色荧光蛋白标记的微管蛋白和微管相关蛋白的方法
第33章 膜系统和膜运输的活细胞成像
第34章 机械应力下的活细胞成像
第35章 基于全内反射荧光显微镜的单分子成像
第36章 基于全内反射荧光显微技术的细胞成像
第37章 活细胞中单个RNA分子的观测与定量分析
附录 注意事项
索引
作者介绍
文摘
序言
用户评价
我是一个对生物学中的可视化技术有浓厚兴趣的爱好者,偶然得知了《活细胞成像》这本书。虽然我并非专业背景,但翻看目录和部分插图,依然让我觉得受益匪浅。这本书似乎能够将我们平时难以想象的微观世界变得触手可及。从书中对不同细胞类型的介绍,到对细胞基本生理过程的展示,让我能够更直观地理解生命是如何在分子层面运作的。我特别被书中关于细胞分裂、细胞迁移等动态过程的描述所吸引,这些都是生命最本质的特征,而这本书似乎能提供观察这些过程的窗口。我喜欢那种能够将科学知识用清晰、易懂的方式呈现出来的书籍,这本书在这一点上做得很好,即使是对于非专业人士,也能感受到科学的魅力和探索的乐趣。
评分最近因为研究方向的需要,我开始涉足细胞生物学领域,而《活细胞成像》这本著作,虽然我还没来得及深入研读,但仅仅是翻阅其中的目录和部分章节,就让我对这个领域有了全新的认识。这本书的编排方式非常独特,它并没有一开始就将读者推向复杂的成像技术细节,而是循序渐进地从细胞的基本结构和动态过程讲起,让我这个初学者能够快速建立起对观察对象的理解。特别是在关于细胞骨架、细胞器运动以及分子在细胞内运输的章节,作者运用了大量的示意图和对比图,生动地展示了这些肉眼不可见的微观世界是如何运作的。我印象深刻的是其中对“活”细胞的定义和解读,它强调的不仅仅是观察静态的结构,更是捕捉生命活动过程中细胞的瞬息万变。这种对“动态”的关注,正是活细胞成像的核心所在,也是吸引我的地方。我期待着能够从这本书中学到如何设计实验,如何选择合适的成像技术来回答生物学问题。
评分我是一名对细胞信号转导和分子动态学感兴趣的研究生。虽然我还没深入阅读《活细胞成像》这本书,但翻阅其章节时,我被书中对细胞内物质运输和分子相互作用的描绘所吸引。我一直对细胞内信号是如何传递、蛋白质是如何定位和互作感到好奇,而这本书提供的视角,让我明白活细胞成像不仅仅是“看”,更是“理解”。书中对微管、肌动蛋白等细胞骨架在介导物质运输中的作用的阐述,以及利用各种显微技术来追踪这些过程的例子,让我看到了将这些抽象的理论具象化的可能。特别是一些关于细胞器动态变化以及囊泡运输的成像分析方法,给我留下了深刻的印象。这本书让我认识到,通过精确的成像技术,我们可以直接观察到细胞内发生的复杂事件,从而深入理解细胞的生命活动。
评分我是一个对生物成像技术充满好奇的本科生,一直想找一本能系统介绍各种成像方法的书。《活细胞成像》这本书,虽然我还没完全读懂,但它给我的感觉是既权威又实用。书中对各种显微镜技术,比如荧光显微镜、共聚焦显微镜,以及最近很热门的超分辨率显微镜,都有详细的介绍。我特别关注的是关于荧光标记的部分,了解到不同的荧光染料、荧光蛋白以及标记方法,对于获得高质量的成像结果至关重要。书中还提到了像FRAP(荧光漂白恢复)和FRET(荧光共振能量转移)这类功能性成像技术,这让我看到了通过成像来研究分子相互作用和动力学的可能性,这对于理解细胞信号传导等复杂过程非常有帮助。这本书的内容深度和广度都非常出色,感觉它不仅仅是停留在技术介绍层面,而是将技术与生物学问题紧密结合,让读者明白为什么需要这些技术,以及如何运用这些技术去解决实际的生物学难题。
评分作为一名在学术界摸爬滚打了多年的研究员,我深知技术更新换代的速度。对于《活细胞成像》这本书,我主要从其理论深度和对未来发展趋势的预判性来审视。书中对早期活细胞成像方法的历史回顾,以及对当前主流技术的原理性剖析,都展现了作者深厚的学术功底。我尤其欣赏的是,作者并没有止步于对现有技术的简单罗列,而是深入探讨了每种技术在分辨率、速度、光毒性等方面的局限性,并积极展望了未来可能的技术突破方向。例如,书中对光学显微成像极限的讨论,以及对新型探测器和光源的介绍,都预示着活细胞成像领域的下一个浪潮。这本书对于我们这些希望站在研究前沿的科研人员来说,无疑是一盏指路明灯,它能帮助我们把握技术发展脉络,提前布局未来的研究方向,从而在激烈的科研竞争中保持领先。
相关图书
本站所有内容均为互联网搜索引擎提供的公开搜索信息,本站不存储任何数据与内容,任何内容与数据均与本站无关,如有需要请联系相关搜索引擎包括但不限于百度,google,bing,sogou 等
© 2026 book.tinynews.org All Rights Reserved. 静思书屋 版权所有